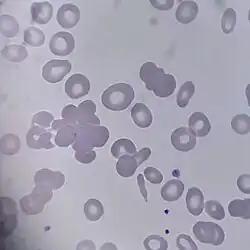

Concentración de hemoglobina corpuscular media

La concentración de hemoglobina corpuscular media, o CHCM, es una medida de la concentración de hemoglobina en un volumen determinado de glóbulos rojos. Se informa como parte del examen completo o CSC (conteo sanguíneo completo).
x
Los rangos de referencia para el hemograma son de 32 a 36 g/dl,[1] o entre 4,9[2] a 5,5[2] mmol/L. Es, por lo tanto, una concentración de masa o molar. No obstante, en muchos casos,[3][4] la CHCM es medida en porcentaje (%) como si fuera una fracción de masa (mHb / mGR). Expresado en números, sin embargo, la CHCM en g/dl y la fracción de masa de la hemoglobina de los glóbulos rojos en %, son idénticos, asumiendo una densidad del eritrocito de 1 g/ml y una cantidad insignificante de hemoglobina en plasma.
Interpretación
La CHCM disminuye ("hipocrómica") en las anemias microcíticas, y es normal ("normocrómica") en las anemias macrocíticas (si bien el tamaño de la célula es más grande, la cantidad de hemoglobina o HCM es alta, por lo que la concentración sigue siendo normal). La CHCM es elevada ("hipercrómicas") en la esferocitosis hereditaria, enfermedad de células falciformes y la enfermedad de la hemoglobina C en homocigotas.[5]
En ocasiones, se puede ver disminuida en pacientes embarazadas. Este estudio se utiliza para dar una guía aproximada del tono rojo que tendrá el eritrocito (más claro = más bajo que el estándar).
Complicaciones con crioaglutininas
Debido a la forma en que los analizadores automáticos cuentan las células sanguíneas, una CHCM muy alta (mayor de 370 g/L) puede indicar que la sangre es de alguien con crioaglutininas. Esto significa que cuando la sangre se enfría a menos de 37 °C los eritrocitos comienzan a agruparse. Como resultado, el analizador puede informar incorrectamente de un número bajo de glóbulos rojos muy densos en las muestras de sangre en las que se ha producido aglutinación.
Este problema suele ser corregido por el laboratorio antes de que el resultado se informe. La sangre se calienta hasta que las células se separan unas de otras, y rápidamente se pasa a través de la máquina mientras aún está caliente. Esta es la prueba más sensible para la anemia por deficiencia de hierro.
Hay 4 pasos para llevar a cabo cuando es recibido del analizador un aumento de la CHCM (> 370 g/L o 37,0 g/dL):
- 1. Volver a mezclar el tubo de EDTA - si se corrige la CHCM, se informa los resultados corregidos
- 2. Incubación a 37 °C - si se corrige la CHCM, se informa los resultados corregidos y se comenta sobre posibles crioaglutininas
- 3. Reemplazo con solución salina - Se reemplaza el plasma con la misma cantidad del diluente que utiliza el analizador, para excluir la interferencia de, por ejemplo, lipemia y autoanticuerpos - si se corrige la CHCM, se informa los resultados corregidos y se comenta sobre la lipemia
- 4. Comprobar la platina del microscopio en busca de esferocitos (esferocitosis hereditaria)
Hematíes aglutinados por presencia de crioaglutininas
Índices de glóbulos rojos
| Examen | Unidad | Límite bajo | Límite alto |
|---|---|---|---|
| Hto (hombre) | % | 38 | 52 |
| Hto (mujer) | % | 35 | 47 |
| Hb (hombre) | g/L | 140 | 180 |
| Hb (mujer) | g/L | 115 | 160 |
| GR (hombre) | x10¹²/L | 4,5 | 6,5 |
| GR (mujer) | x10¹²/L | 3,8 | 5,8 |
| VCM | fL | 80 | 98 |
| HCM | pg | 26 | 34 |
| CHCM | g/dl | 32 | 36 |
Véase también
Referencias
- ↑ http://www.nlm.nih.gov/medlineplus/ency/article/003648.htm
- ↑ a b Derived from mass concentration, using molar mass of 64,458 g/mol (Van Beekvelt MC, Colier WN, Wevers RA, Van Engelen BG (2001). «Performance of near-infrared spectroscopy in measuring local O2 consumption and blood flow in skeletal muscle». J Appl Physiol 90 (2): 511-519. PMID 11160049.). 1 g/dL = 0.1551 mmol/L
- ↑ Blood Test Results - Normal Ranges Archivado el 2 de noviembre de 2012 en Wayback Machine. Bloodbook.Com. Retrieved on Jan 7, 2009
- ↑ MedicineNet > Definition of MCHC Archivado el 6 de agosto de 2011 en Wayback Machine. Last Editorial Review: 7/21/1999
- ↑ Rifkind, David; Cohen, Alan S. (2002). The Pediatric Abacus. Informa Healthcare. pp. 54. ISBN 1-84214-147-3.
- Esta obra contiene una traducción derivada de «Mean corpuscular hemoglobin concentration» de Wikipedia en inglés, publicada por sus editores bajo la Licencia de documentación libre de GNU y la Licencia Creative Commons Atribución-CompartirIgual 4.0 Internacional.